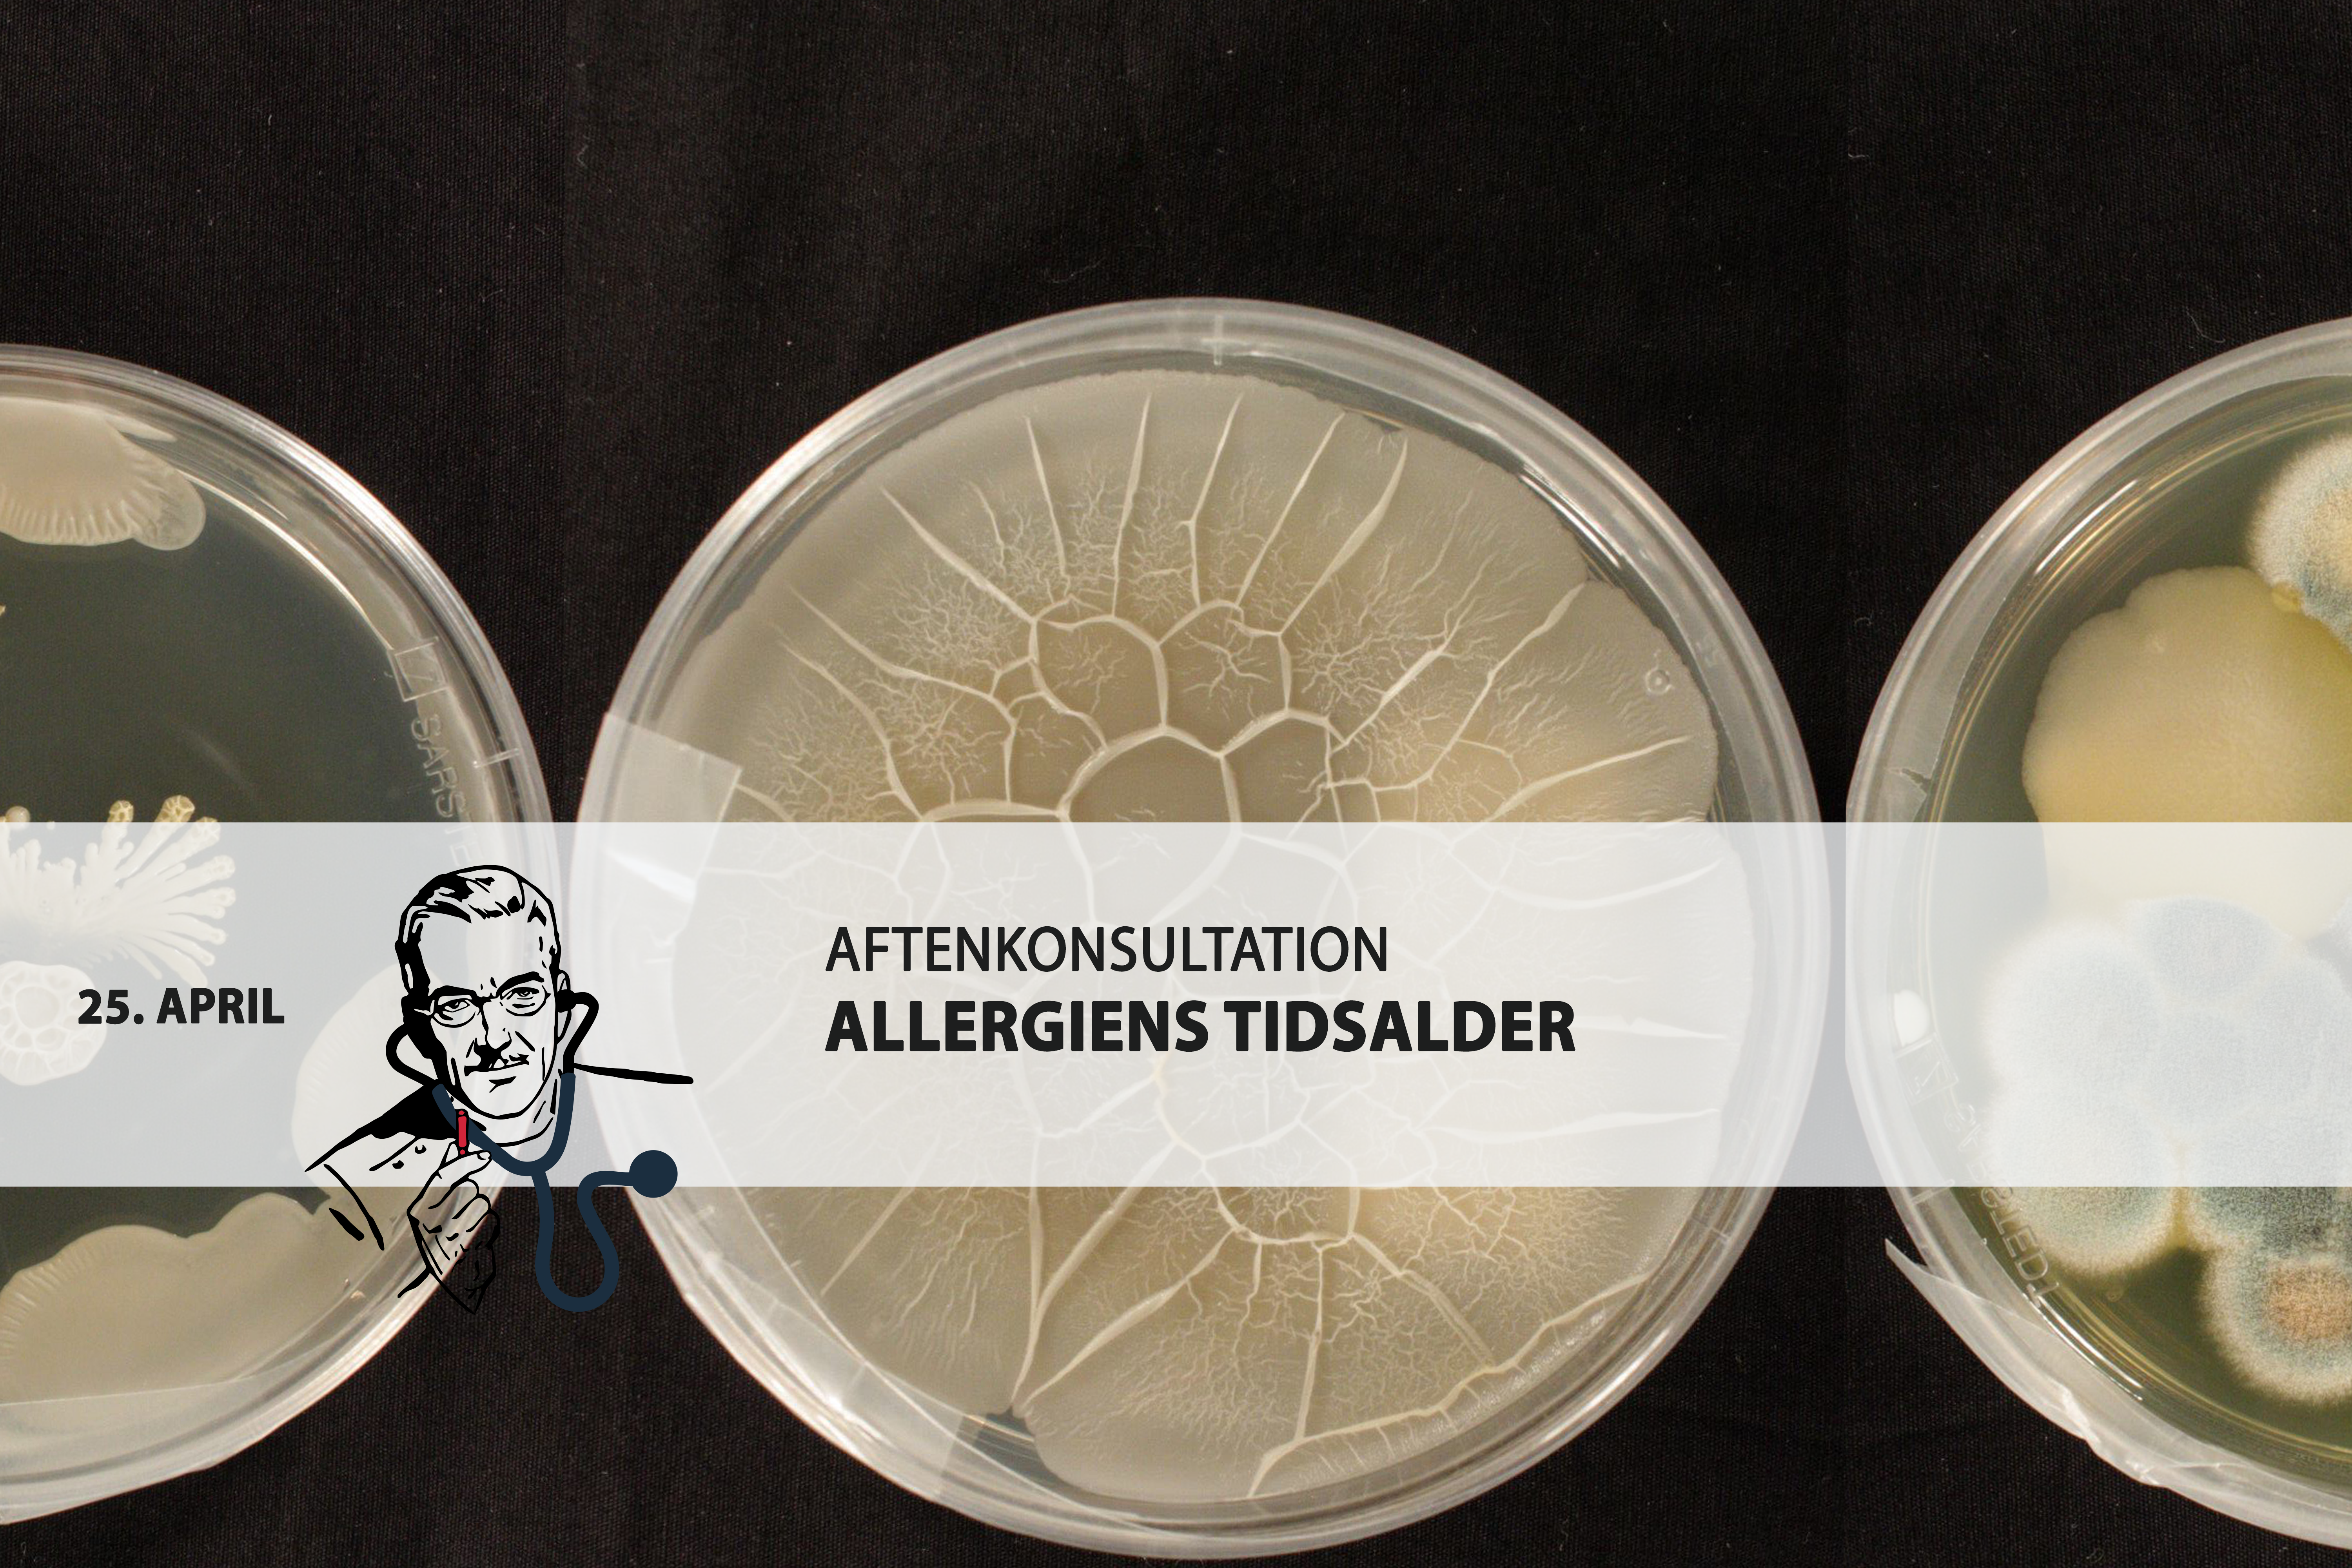

Universitetsavisen
Nørregade 10
1165 København K
Tlf: 21 17 95 65 (man-fre kl. 9-15)
E-mail: uni-avis@adm.ku.dk
Foredrag
Foredrag — De seneste årtier har man i vestlige lande registreret en eksplosiv stigning i tilfælde af allergier. Forskerne står tilbage med et spørgsmål: Hvorfor får flere allergi? Måske skal svaret findes i det faktum, at vi lever mere renligt og sterilt end tidligere.
Date & Time:
Place:
Medicinsk Museion, Bredgade 62, 1260. København K
Hosted by:
Medicinsk Museion
Cost:
75 kr. for studerende
De seneste årtier har man i vestlige lande registreret en eksplosiv stigning i tilfælde af allergier. Forskerne står tilbage med et spørgsmål: Hvorfor får flere allergi? Måske skal svaret findes i det faktum, at vi lever mere renligt og sterilt end tidligere.
Vi slår denne aften dørene op til en Aftenkonsultation om snavs, skidt og allergi. Det bliver op til professor Hanne Frøkiær at skille skidt fra kanel i diskussionen om hygiejnehypotesen – idéen om, at der er en sammenhæng mellem renlighed og allergi. Bliv klogere på allergier og mave-tarmbakterier, når Hanne Frøkiær deler ud af sin ekspertise.
Efterfølgende vil museumsinspektør Malthe Bjerregaard sætte idéer om renlighed og hygiejne ind i et historisk perspektiv – hvordan lærte vi at frygte baciller, smuds og støv, og hvordan blev den danske befolkning velsoigneret?
Medvirkende:
Hanne Frøkiær – Professor ved Institut for Veterinær- og husdyrsvidenskab, Københavns Universitet.
Malthe Bjerregaard – Museumsinspektør ved Medicinsk Museion, Københavns Universitet.
Dørene åbner kl. 18.30. Efter konsultationen udstedes en recept på et glas, og det vil være muligt at tage en spadseretur rundt i museets udstillinger. Begge er inkluderet i billetprisen.